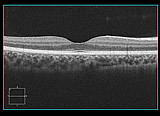
網膜の断層像

![]()
各項目をクリックしてご覧ください。

光干渉断層計(OCT)
- 光干渉断層計(OCT)は、網膜(カメラで例えるとフィルムにあたる部分)の断層画像を撮影します。主に、加齢黄斑変性症、糖尿病黄斑症、黄斑円孔、網膜剥離、黄斑上膜、緑内障などの疾患を精密検査するために行います。
- これまでの眼底検査では行えなかった目の奥にある網膜の立体的な情報を得ることができます。
網膜の断層像

ハンフリー自動視野計
- 中心部の視野を測定します。
- 緑内障の早期発見にも非常に有用です。

自動視野計 アイモvifa
- 中心部の視野を測定します。
- 両眼同時に測定することで検査時間の短縮が
- 可能です。

ゴールドマン視野計
- 全体の視野の形状を測定

オートレフケラト/トノ/パキメータ
- 一般的な測定機器と比べて測定ポイントが多く、より正確に様々な計測が可能です。
- ・他覚的屈折度測定
- ・角膜曲率半径測定
- ・眼圧測定
- ・角膜厚測定
- ・調節力測定
- また水晶体の混濁の状態も撮影可能です。

スポットビジョンスクリーナー
- 離れた場所から屈折の程度や眼位の状態を測定できます。
- 特にお子様の測定に適しており、近年では多くの自治体で検診に使用されています。

オートレフケラトメーター
- 目の屈折状態を自動的に測定

超音波診断装置(Bモード)
- 眼底が観察できない時に、目の中の状態を検査する

多目的両眼視スクリーナ(OPUS)
- 両眼視機能(眼位・同時視・融像・立体視)を検査













